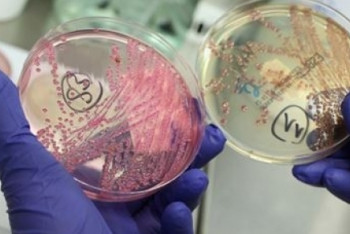

Все новости за 22 октября 2018
-
-
Ситуация с менингитом в Астане стабильная
На сегодняшний день в детской инфекционной больнице Астаны проходят лечение 14 детей разных возрастов.
-
В МСХ РК прокомментировали происшествие на морском судне "NAZMEHR"
По фумигации отгруженного на экспорт зерна возникли вопросы.
-
32 млрд тенге инвестиций будет привлечено в ЗКО
Известно, что акимат области будет оказывать поддержку инвесторам на протяжении реализации проектов.
-
В Словении почтили память казахстанского героя Великой Отечественной войны
В рамках поминального мероприятия состоялась церемония установки надгробной плиты на могиле героя.
-
Фейковую рассылку о ЕНТ прокомментировали в МОН
Эксперты данную информацию оценивают, как попытку выдать желаемое за действительность.
-
Айгуль Куспан назначена главой представительства Казахстана в ЕС и НАТО
Также она назначена Чрезвычайным и Полномочным Послом Республики Казахстан в Великом Герцогстве Люксембург.
-
Начальника ДЧС Алматинской области отправили под домашний арест за взятку
Он подозревается в получении взятки в сумме 300 000 тенге.
-
Около 200 кукол ручной работы представят российские и казахстанские мастера в Алматы
Эксклюзивные куклы будут размером от девяти сантиметров, до 1,5 метра с применением большого количества разных техник, в частности бисероплетения.
-
МИД решил вопрос казахстанских студентов, оставшихся на улице в Китае
Студента размещены в общежитиях.
-
Министр торговли США посетит Казахстан
В ходе визита Уилбура Росса в Астану планируется обсудить дальнейшее развитие торгово-экономического и инвестиционного сотрудничества между Казахстаном и США.
-
Одноклассники госпитализированных с подозрением на менингит школьников не заразились инфекцией
За госпитализированными детьми медперсонал ведёт постоянное наблюдение.
-
Мангистауская область первой в Казахстане полностью отказалась от аналогового сигнала
Область перешла на цифровое эфирное телевещание.
-
Отравление граждан Ирана на Каспийском море прокомментировали в МИД РК
На данный момент иранская сторона в МИД РК не обращалась.
-
Около 12 тысяч казахстанцев могут депортировать из Южной Кореи
Правительство Южной Кореи с первого октября начало акцию "Зеленый коридор" по выявлению иностранных граждан, находящихся на территории страны нелегально.
-
В Астане госпитализирован мужчина с подозрением на менингококковую инфекцию
Состояние у пациента стабильное, врачи отмечают положительную динамику.
-
Подозреваемым по делу об убийстве Дениса Тена снова продлили арест
Для расследования дела подозреваемым добавили 15 суток.
-
Назарбаев подписал указ о мерах реализации Послания
О мерах по реализации Послания Главы государства народу Казахстана от 5 октября 2018 года "Рост благосостояния казахстанцев: повышение доходов и качества жизни"
-
Владельцы недвижимости в Казахстане смогут узнать о прописанных жильцах онлайн
На портале eGov.kz доступна новая услуга "домовая книга" в режиме онлайн.
-
День работника леса впервые отметили в Акмолинской области
Принявший участие в торжественном мероприятии аким Акмолинской области Малик Мурзалин поздравил представителей лесной отрасли с профессиональным праздником.
-
Часть крыши автобусной остановки обвалилась на голову мужчине в Усть-Каменогорске
-
Что акимат Алматы делает для создания комфортной городской среды
В южной столице реконструировано уже две трети исторического центра города, отремонтированы 524 улицы и почти 1400 старых дворов.
-
Фильм "Амре" стал обладателем Silver Screen Award на Голливудском кинофестивале
Теперь фильм, как обладатель награды, будет бороться с 16-ю странами в финале за главный приз фестиваля.
-
К трём годам лишения свободы суд приговорил экс-начальника колонии за покровительство Ермегияеву
Его заместителя, майора юстиции Талгата Мусаева осудили на два года лишения свободы с отбыванием наказания в учреждении минимальной безопасности.
-
Тепло придёт в Казахстан в ближайшие трое суток
По данным синоптиков, антициклон, долгое время удерживавший теплую погоду над Европейской частью России, начал смещаться на восток.
-
Стали известны сроки газификации Астаны
Ориентировочный срок получения заключения – четвёртый квартал 2018 года. Строительство газораспределительных сетей в Астане согласно ТЭО разделено на три очереди.
-
Команда из Казахстана завоевала первое место в конкурсе Nasa
Казахстанская команда представила свою работу для анализа данных вулканов и астероидов.
-
KASE: Курс доллара составил 365 тенге
На Казахстанской фондовой бирже (KASE) закончилась утренняя торговая сессия по иностранным валютам.
-
Казахстанцы больше всего тратятся на еду
Основной статьей затрат являются потребительские расходы, которые сконсолидировали 92,8% всех расходов.
-
Казахстанский спецназ признан лучшим на соревнованиях в Китае
В соревнованиях, которые проходят с 18 по 22 октября, принимают участие более 100 лучших снайперов из 21 страны, включая Китай, Беларусь, Венгрию, Израиль и Пакистан.
-
До конца 2018 года в Казахстане отменят трудовые книжки
Бумажную трудовую книжку переведут в электронный формат.
-
Алматы стал лидером по безналичному расчёту в Казахстане - исследование
По итогам августа этого года объём безналичных платежей по всему Казахстану по картам составил свыше 519 млрд тенге, из них 338,6 млрд тенге приходится на южную столицу.
-
Учиться из дома смогут школьники Астаны
Проект дистанционного обучения реализуется в столичной школе-гимназии № 22.
-
Кайрат Нуртас стал Послом здоровья в Казахстане
Также почётное звание от Министерства здравоохранения РК получили Каракат Абильдина, Юрий Мельниченко, Нурлан Алимжанов, Ибрагим Ескендір и Данияр Жумадилов.
-
Сборная Казахстана вошла в тройку лучших на чемпионате мира по дзюдо
Казахстанцы обыграли команды Германии и Франции, однако уступили Бразилии.
-
Караганду предложили назвать "Терриконовой долиной"
В течение четырёх дней в Караганде проходил Международный форум IT-WEEKEND.KZ - 2018. На мероприятие съехались специалисты высоких технологий со всего региона и других стран.
-
Данияр Елеусинов взлетел на 39 позиций в мировом рейтинге
Четвёртая победа в карьере, позволила казахстанскому боксёру улучшить своё положение в рейтинге BoxRec полусреднего веса и расположиться на 224 месте.
-
Исекешев рассказал о преобразованиях, улучшающих благосостояние казахстанцев
Руководитель Администрации Президента выступил на открытии семинар-тренинга "Трансформационное лидерство в условиях меняющегося мира" с мотивационной лекцией.
-
Подробности гибели журналистки в Алматы рассказали в полиции
Молодая женщина ушла из дома после семейной ссоры.
-
Погода без осадков сохранится на большей части Казахстана 22 октября
Лишь в северной половине республики ожидается неустойчивый характер погоды.
Наверх
![]() Ситуация с менингитом в Астане стабильнаяНа сегодняшний день в детской инфекционной больнице Астаны проходят лечение 14 детей разных возрастов.22.10.20183739
Ситуация с менингитом в Астане стабильнаяНа сегодняшний день в детской инфекционной больнице Астаны проходят лечение 14 детей разных возрастов.22.10.20183739![]() В МСХ РК прокомментировали происшествие на морском судне "NAZMEHR"По фумигации отгруженного на экспорт зерна возникли вопросы.22.10.20182823
В МСХ РК прокомментировали происшествие на морском судне "NAZMEHR"По фумигации отгруженного на экспорт зерна возникли вопросы.22.10.20182823![]() 32 млрд тенге инвестиций будет привлечено в ЗКОИзвестно, что акимат области будет оказывать поддержку инвесторам на протяжении реализации проектов.22.10.20182953
32 млрд тенге инвестиций будет привлечено в ЗКОИзвестно, что акимат области будет оказывать поддержку инвесторам на протяжении реализации проектов.22.10.20182953![]() В Словении почтили память казахстанского героя Великой Отечественной войныВ рамках поминального мероприятия состоялась церемония установки надгробной плиты на могиле героя.22.10.20184003
В Словении почтили память казахстанского героя Великой Отечественной войныВ рамках поминального мероприятия состоялась церемония установки надгробной плиты на могиле героя.22.10.20184003![]() Фейковую рассылку о ЕНТ прокомментировали в МОНЭксперты данную информацию оценивают, как попытку выдать желаемое за действительность.22.10.20187867
Фейковую рассылку о ЕНТ прокомментировали в МОНЭксперты данную информацию оценивают, как попытку выдать желаемое за действительность.22.10.20187867![]() Айгуль Куспан назначена главой представительства Казахстана в ЕС и НАТОТакже она назначена Чрезвычайным и Полномочным Послом Республики Казахстан в Великом Герцогстве Люксембург.22.10.20182273
Айгуль Куспан назначена главой представительства Казахстана в ЕС и НАТОТакже она назначена Чрезвычайным и Полномочным Послом Республики Казахстан в Великом Герцогстве Люксембург.22.10.20182273![]() Начальника ДЧС Алматинской области отправили под домашний арест за взяткуОн подозревается в получении взятки в сумме 300 000 тенге.22.10.20183036
Начальника ДЧС Алматинской области отправили под домашний арест за взяткуОн подозревается в получении взятки в сумме 300 000 тенге.22.10.20183036![]() Около 200 кукол ручной работы представят российские и казахстанские мастера в АлматыЭксклюзивные куклы будут размером от девяти сантиметров, до 1,5 метра с применением большого количества разных техник, в частности бисероплетения.22.10.20188815
Около 200 кукол ручной работы представят российские и казахстанские мастера в АлматыЭксклюзивные куклы будут размером от девяти сантиметров, до 1,5 метра с применением большого количества разных техник, в частности бисероплетения.22.10.20188815![]() МИД решил вопрос казахстанских студентов, оставшихся на улице в КитаеСтудента размещены в общежитиях.22.10.20183888
МИД решил вопрос казахстанских студентов, оставшихся на улице в КитаеСтудента размещены в общежитиях.22.10.20183888![]() Министр торговли США посетит КазахстанВ ходе визита Уилбура Росса в Астану планируется обсудить дальнейшее развитие торгово-экономического и инвестиционного сотрудничества между Казахстаном и США.22.10.20183635
Министр торговли США посетит КазахстанВ ходе визита Уилбура Росса в Астану планируется обсудить дальнейшее развитие торгово-экономического и инвестиционного сотрудничества между Казахстаном и США.22.10.20183635![]() Одноклассники госпитализированных с подозрением на менингит школьников не заразились инфекциейЗа госпитализированными детьми медперсонал ведёт постоянное наблюдение.22.10.20183080
Одноклассники госпитализированных с подозрением на менингит школьников не заразились инфекциейЗа госпитализированными детьми медперсонал ведёт постоянное наблюдение.22.10.20183080![]() Мангистауская область первой в Казахстане полностью отказалась от аналогового сигналаОбласть перешла на цифровое эфирное телевещание.22.10.20185474
Мангистауская область первой в Казахстане полностью отказалась от аналогового сигналаОбласть перешла на цифровое эфирное телевещание.22.10.20185474![]() Отравление граждан Ирана на Каспийском море прокомментировали в МИД РКНа данный момент иранская сторона в МИД РК не обращалась.22.10.20182259
Отравление граждан Ирана на Каспийском море прокомментировали в МИД РКНа данный момент иранская сторона в МИД РК не обращалась.22.10.20182259![]() Около 12 тысяч казахстанцев могут депортировать из Южной КореиПравительство Южной Кореи с первого октября начало акцию "Зеленый коридор" по выявлению иностранных граждан, находящихся на территории страны нелегально.22.10.20186445
Около 12 тысяч казахстанцев могут депортировать из Южной КореиПравительство Южной Кореи с первого октября начало акцию "Зеленый коридор" по выявлению иностранных граждан, находящихся на территории страны нелегально.22.10.20186445![]() В Астане госпитализирован мужчина с подозрением на менингококковую инфекциюСостояние у пациента стабильное, врачи отмечают положительную динамику.22.10.20183702
В Астане госпитализирован мужчина с подозрением на менингококковую инфекциюСостояние у пациента стабильное, врачи отмечают положительную динамику.22.10.20183702![]() Подозреваемым по делу об убийстве Дениса Тена снова продлили арестДля расследования дела подозреваемым добавили 15 суток.22.10.20184348
Подозреваемым по делу об убийстве Дениса Тена снова продлили арестДля расследования дела подозреваемым добавили 15 суток.22.10.20184348![]() Назарбаев подписал указ о мерах реализации ПосланияО мерах по реализации Послания Главы государства народу Казахстана от 5 октября 2018 года "Рост благосостояния казахстанцев: повышение доходов и качества жизни"22.10.20182719
Назарбаев подписал указ о мерах реализации ПосланияО мерах по реализации Послания Главы государства народу Казахстана от 5 октября 2018 года "Рост благосостояния казахстанцев: повышение доходов и качества жизни"22.10.20182719![]() Владельцы недвижимости в Казахстане смогут узнать о прописанных жильцах онлайнНа портале eGov.kz доступна новая услуга "домовая книга" в режиме онлайн.22.10.20188835
Владельцы недвижимости в Казахстане смогут узнать о прописанных жильцах онлайнНа портале eGov.kz доступна новая услуга "домовая книга" в режиме онлайн.22.10.20188835![]() День работника леса впервые отметили в Акмолинской областиПринявший участие в торжественном мероприятии аким Акмолинской области Малик Мурзалин поздравил представителей лесной отрасли с профессиональным праздником.22.10.20185852
День работника леса впервые отметили в Акмолинской областиПринявший участие в торжественном мероприятии аким Акмолинской области Малик Мурзалин поздравил представителей лесной отрасли с профессиональным праздником.22.10.20185852![]() Часть крыши автобусной остановки обвалилась на голову мужчине в Усть-КаменогорскеМужчина не пострадал.22.10.20183664
Часть крыши автобусной остановки обвалилась на голову мужчине в Усть-КаменогорскеМужчина не пострадал.22.10.20183664![]() Что акимат Алматы делает для создания комфортной городской средыВ южной столице реконструировано уже две трети исторического центра города, отремонтированы 524 улицы и почти 1400 старых дворов.22.10.20185203
Что акимат Алматы делает для создания комфортной городской средыВ южной столице реконструировано уже две трети исторического центра города, отремонтированы 524 улицы и почти 1400 старых дворов.22.10.20185203![]() Фильм "Амре" стал обладателем Silver Screen Award на Голливудском кинофестивалеТеперь фильм, как обладатель награды, будет бороться с 16-ю странами в финале за главный приз фестиваля.22.10.20184173
Фильм "Амре" стал обладателем Silver Screen Award на Голливудском кинофестивалеТеперь фильм, как обладатель награды, будет бороться с 16-ю странами в финале за главный приз фестиваля.22.10.20184173![]() К трём годам лишения свободы суд приговорил экс-начальника колонии за покровительство ЕрмегияевуЕго заместителя, майора юстиции Талгата Мусаева осудили на два года лишения свободы с отбыванием наказания в учреждении минимальной безопасности.22.10.20184916
К трём годам лишения свободы суд приговорил экс-начальника колонии за покровительство ЕрмегияевуЕго заместителя, майора юстиции Талгата Мусаева осудили на два года лишения свободы с отбыванием наказания в учреждении минимальной безопасности.22.10.20184916![]() Тепло придёт в Казахстан в ближайшие трое сутокПо данным синоптиков, антициклон, долгое время удерживавший теплую погоду над Европейской частью России, начал смещаться на восток.22.10.20184030
Тепло придёт в Казахстан в ближайшие трое сутокПо данным синоптиков, антициклон, долгое время удерживавший теплую погоду над Европейской частью России, начал смещаться на восток.22.10.20184030![]() Стали известны сроки газификации АстаныОриентировочный срок получения заключения – четвёртый квартал 2018 года. Строительство газораспределительных сетей в Астане согласно ТЭО разделено на три очереди.22.10.20185023
Стали известны сроки газификации АстаныОриентировочный срок получения заключения – четвёртый квартал 2018 года. Строительство газораспределительных сетей в Астане согласно ТЭО разделено на три очереди.22.10.20185023![]() Команда из Казахстана завоевала первое место в конкурсе NasaКазахстанская команда представила свою работу для анализа данных вулканов и астероидов.22.10.20185964
Команда из Казахстана завоевала первое место в конкурсе NasaКазахстанская команда представила свою работу для анализа данных вулканов и астероидов.22.10.20185964![]() KASE: Курс доллара составил 365 тенгеНа Казахстанской фондовой бирже (KASE) закончилась утренняя торговая сессия по иностранным валютам.22.10.20182990
KASE: Курс доллара составил 365 тенгеНа Казахстанской фондовой бирже (KASE) закончилась утренняя торговая сессия по иностранным валютам.22.10.20182990![]() Казахстанцы больше всего тратятся на едуОсновной статьей затрат являются потребительские расходы, которые сконсолидировали 92,8% всех расходов.22.10.20183106
Казахстанцы больше всего тратятся на едуОсновной статьей затрат являются потребительские расходы, которые сконсолидировали 92,8% всех расходов.22.10.20183106![]() Казахстанский спецназ признан лучшим на соревнованиях в КитаеВ соревнованиях, которые проходят с 18 по 22 октября, принимают участие более 100 лучших снайперов из 21 страны, включая Китай, Беларусь, Венгрию, Израиль и Пакистан.22.10.20185364
Казахстанский спецназ признан лучшим на соревнованиях в КитаеВ соревнованиях, которые проходят с 18 по 22 октября, принимают участие более 100 лучших снайперов из 21 страны, включая Китай, Беларусь, Венгрию, Израиль и Пакистан.22.10.20185364![]() До конца 2018 года в Казахстане отменят трудовые книжкиБумажную трудовую книжку переведут в электронный формат.22.10.201820753
До конца 2018 года в Казахстане отменят трудовые книжкиБумажную трудовую книжку переведут в электронный формат.22.10.201820753![]() Алматы стал лидером по безналичному расчёту в Казахстане - исследованиеПо итогам августа этого года объём безналичных платежей по всему Казахстану по картам составил свыше 519 млрд тенге, из них 338,6 млрд тенге приходится на южную столицу.22.10.20182471
Алматы стал лидером по безналичному расчёту в Казахстане - исследованиеПо итогам августа этого года объём безналичных платежей по всему Казахстану по картам составил свыше 519 млрд тенге, из них 338,6 млрд тенге приходится на южную столицу.22.10.20182471![]() Учиться из дома смогут школьники АстаныПроект дистанционного обучения реализуется в столичной школе-гимназии № 22.22.10.20189361
Учиться из дома смогут школьники АстаныПроект дистанционного обучения реализуется в столичной школе-гимназии № 22.22.10.20189361![]() Кайрат Нуртас стал Послом здоровья в КазахстанеТакже почётное звание от Министерства здравоохранения РК получили Каракат Абильдина, Юрий Мельниченко, Нурлан Алимжанов, Ибрагим Ескендір и Данияр Жумадилов.22.10.201813789
Кайрат Нуртас стал Послом здоровья в КазахстанеТакже почётное звание от Министерства здравоохранения РК получили Каракат Абильдина, Юрий Мельниченко, Нурлан Алимжанов, Ибрагим Ескендір и Данияр Жумадилов.22.10.201813789![]() Сборная Казахстана вошла в тройку лучших на чемпионате мира по дзюдоКазахстанцы обыграли команды Германии и Франции, однако уступили Бразилии.22.10.20184757
Сборная Казахстана вошла в тройку лучших на чемпионате мира по дзюдоКазахстанцы обыграли команды Германии и Франции, однако уступили Бразилии.22.10.20184757![]() Караганду предложили назвать "Терриконовой долиной"В течение четырёх дней в Караганде проходил Международный форум IT-WEEKEND.KZ - 2018. На мероприятие съехались специалисты высоких технологий со всего региона и других стран.22.10.201819002
Караганду предложили назвать "Терриконовой долиной"В течение четырёх дней в Караганде проходил Международный форум IT-WEEKEND.KZ - 2018. На мероприятие съехались специалисты высоких технологий со всего региона и других стран.22.10.201819002![]() Данияр Елеусинов взлетел на 39 позиций в мировом рейтингеЧетвёртая победа в карьере, позволила казахстанскому боксёру улучшить своё положение в рейтинге BoxRec полусреднего веса и расположиться на 224 месте.22.10.20184336
Данияр Елеусинов взлетел на 39 позиций в мировом рейтингеЧетвёртая победа в карьере, позволила казахстанскому боксёру улучшить своё положение в рейтинге BoxRec полусреднего веса и расположиться на 224 месте.22.10.20184336![]() Исекешев рассказал о преобразованиях, улучшающих благосостояние казахстанцевРуководитель Администрации Президента выступил на открытии семинар-тренинга "Трансформационное лидерство в условиях меняющегося мира" с мотивационной лекцией.22.10.20183330
Исекешев рассказал о преобразованиях, улучшающих благосостояние казахстанцевРуководитель Администрации Президента выступил на открытии семинар-тренинга "Трансформационное лидерство в условиях меняющегося мира" с мотивационной лекцией.22.10.20183330![]() Подробности гибели журналистки в Алматы рассказали в полицииМолодая женщина ушла из дома после семейной ссоры.22.10.201824675
Подробности гибели журналистки в Алматы рассказали в полицииМолодая женщина ушла из дома после семейной ссоры.22.10.201824675![]() Погода без осадков сохранится на большей части Казахстана 22 октябряЛишь в северной половине республики ожидается неустойчивый характер погоды.22.10.20184108
Погода без осадков сохранится на большей части Казахстана 22 октябряЛишь в северной половине республики ожидается неустойчивый характер погоды.22.10.20184108